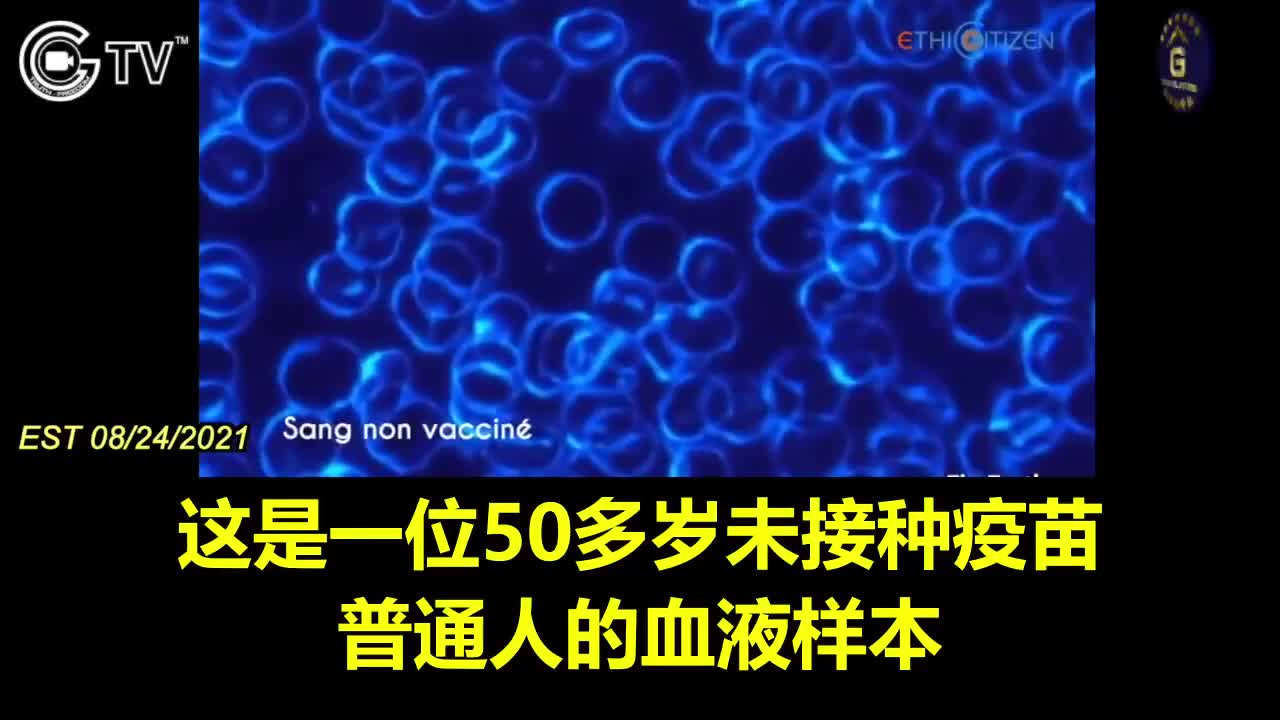

Premium Only Content
This video is only available to Rumble Premium subscribers. Subscribe to
enjoy exclusive content and ad-free viewing.
打疫苗後 紅血球都黏成一串了
Loading comments...
-
 UPCOMING
UPCOMING
Owen Shroyer
8 minutes agoOwen Report - 10-22-2025 - Tucker Carlson SELLS OUT TPUSA Event
-

The Quartering
2 hours agoDangerous ICE Tracker App, Luigi Mangione Bombshell, H1-B's Blown Out, EBT Meltdowns!
93.4K14 -
 LIVE
LIVE
Mally_Mouse
1 hour ago📣Telescreen Talks - LIVE!
168 watching -
 1:57:29
1:57:29
DeVory Darkins
16 hours ago $34.27 earnedDemocrats drop SHOCKING Update regarding ICE Agents - Myron Gaines
117K54 -
 21:24
21:24
Professor Nez
1 hour ago🚨WOW! Trump got EMOTIONAL when RFK Jr. Said THIS!
11.5K13 -
 LIVE
LIVE
Jeff Ahern
1 hour agoNever woke Wednesday with Jeff Ahern
138 watching -
 1:06:21
1:06:21
Timcast
4 hours agoLiberals DEFEND Nazi Tattoo On Communist Democrat Senate Candidate, ITS A CULT
136K148 -
 LIVE
LIVE
Side Scrollers Podcast
2 days ago🔴FIRST EVER RUMBLE SUB-A-THON🔴DAY 3🔴100% REVENUE HELPS CHANGE CULTURE!
1,324 watching -
 25:57
25:57
The Kevin Trudeau Show Limitless
5 hours agoThe Sound Of Control: This Is How They Program You
13.6K7 -
 LIVE
LIVE
Dr Disrespect
4 hours ago🔴LIVE - DR DISRESPECT - BATTLEFIELD 6 KILL CHALLENGE - VS VISS
1,182 watching